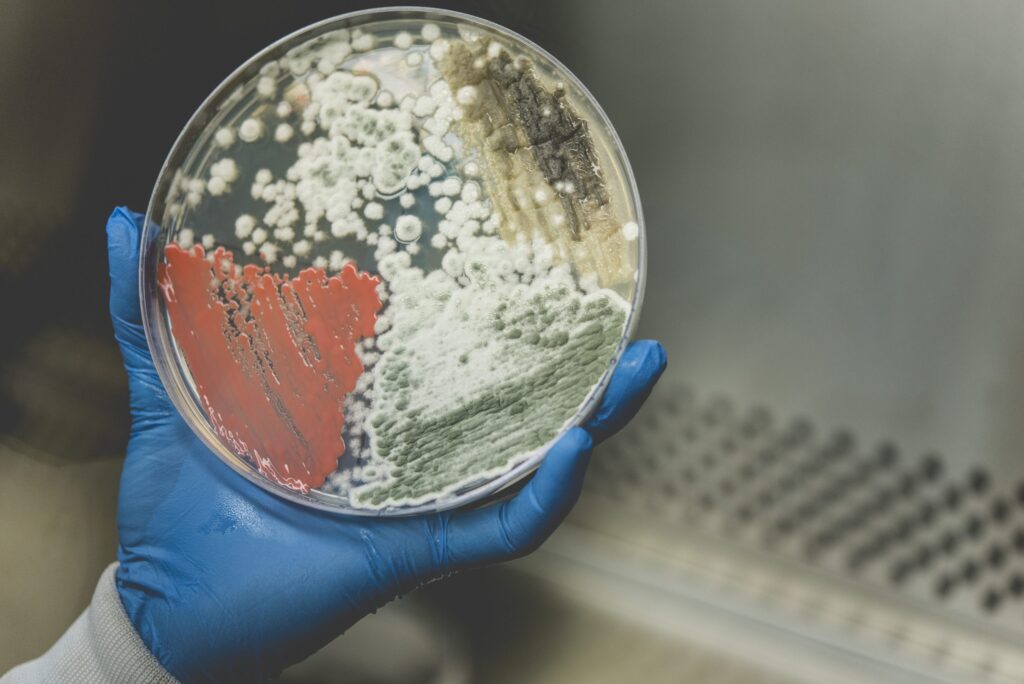

Dans un contexte marqué par les changements climatiques, la perte de biodiversité, la pression croissante exercée sur les ressources naturelles et les préoccupations en matière de santé publique; tous s’entendent sur l’importance de miser sur la bioéconomie.

Définie comme l’activité économique associée à l’invention, au développement et à la production de bioproduits et de procédés biologiques, la bioéconomie s’appuie sur l’utilisation de biomasse, en tout ou en partie, provenant de l’agriculture, de la foresterie, des pêches et de l’aquaculture. Elle contribue au remplacement de ressources fossiles, de produits chimiques et de matières industrielles non renouvelables par des options plus écologiques, en plus de trouver de nouvelles utilités aux résidus et coproduits.

Un secteur d’activité au grand potentiel et offrant des opportunités on ne peut plus motivantes pour l’équipe de Biopterre, dont l’expertise s’articule autour des biotechnologies et des produits horticoles, de la biomasse et des technologies environnementales, des produits forestiers non ligneux et de l’agroforesterie, des mycotechnologies et des cultures intelligentes. Concrètement, l’équipe composée d’experts en recherche appliquée accompagne les entreprises dans leurs projets d’innovation, par exemple : développement de biostimulant, valorisation de coproduits issus de la biotransformation de biomasse, culture de plantes d’intérêt en systèmes agroforestiers, production d’enzymes par fermentation en substrat solide, conception d’écomatériaux, optimisation d’outils de phénotypage pour la quantification de molécules, etc. Appuyée par des infrastructures de pointe, l’équipe multidisciplinaire de Biopterre allie agronomie, biologie, ingénierie de procédé et spécialiste de l’environnement.

La bioéconomie est un domaine où l’inventivité et l’ouverture sont essentielles. Ces qualités animent Biopterre, reconnue comme acteur stratégique et collaborateur engagé dans le succès de ses partenaires. C’est motivé par cette grande mission que l’équipe de Biopterre s’investit dans l’accompagnement des entreprises pour la réalisation de leurs projets d’innovation, contribuant ainsi à l’essor de la bioéconomie au Québec.
